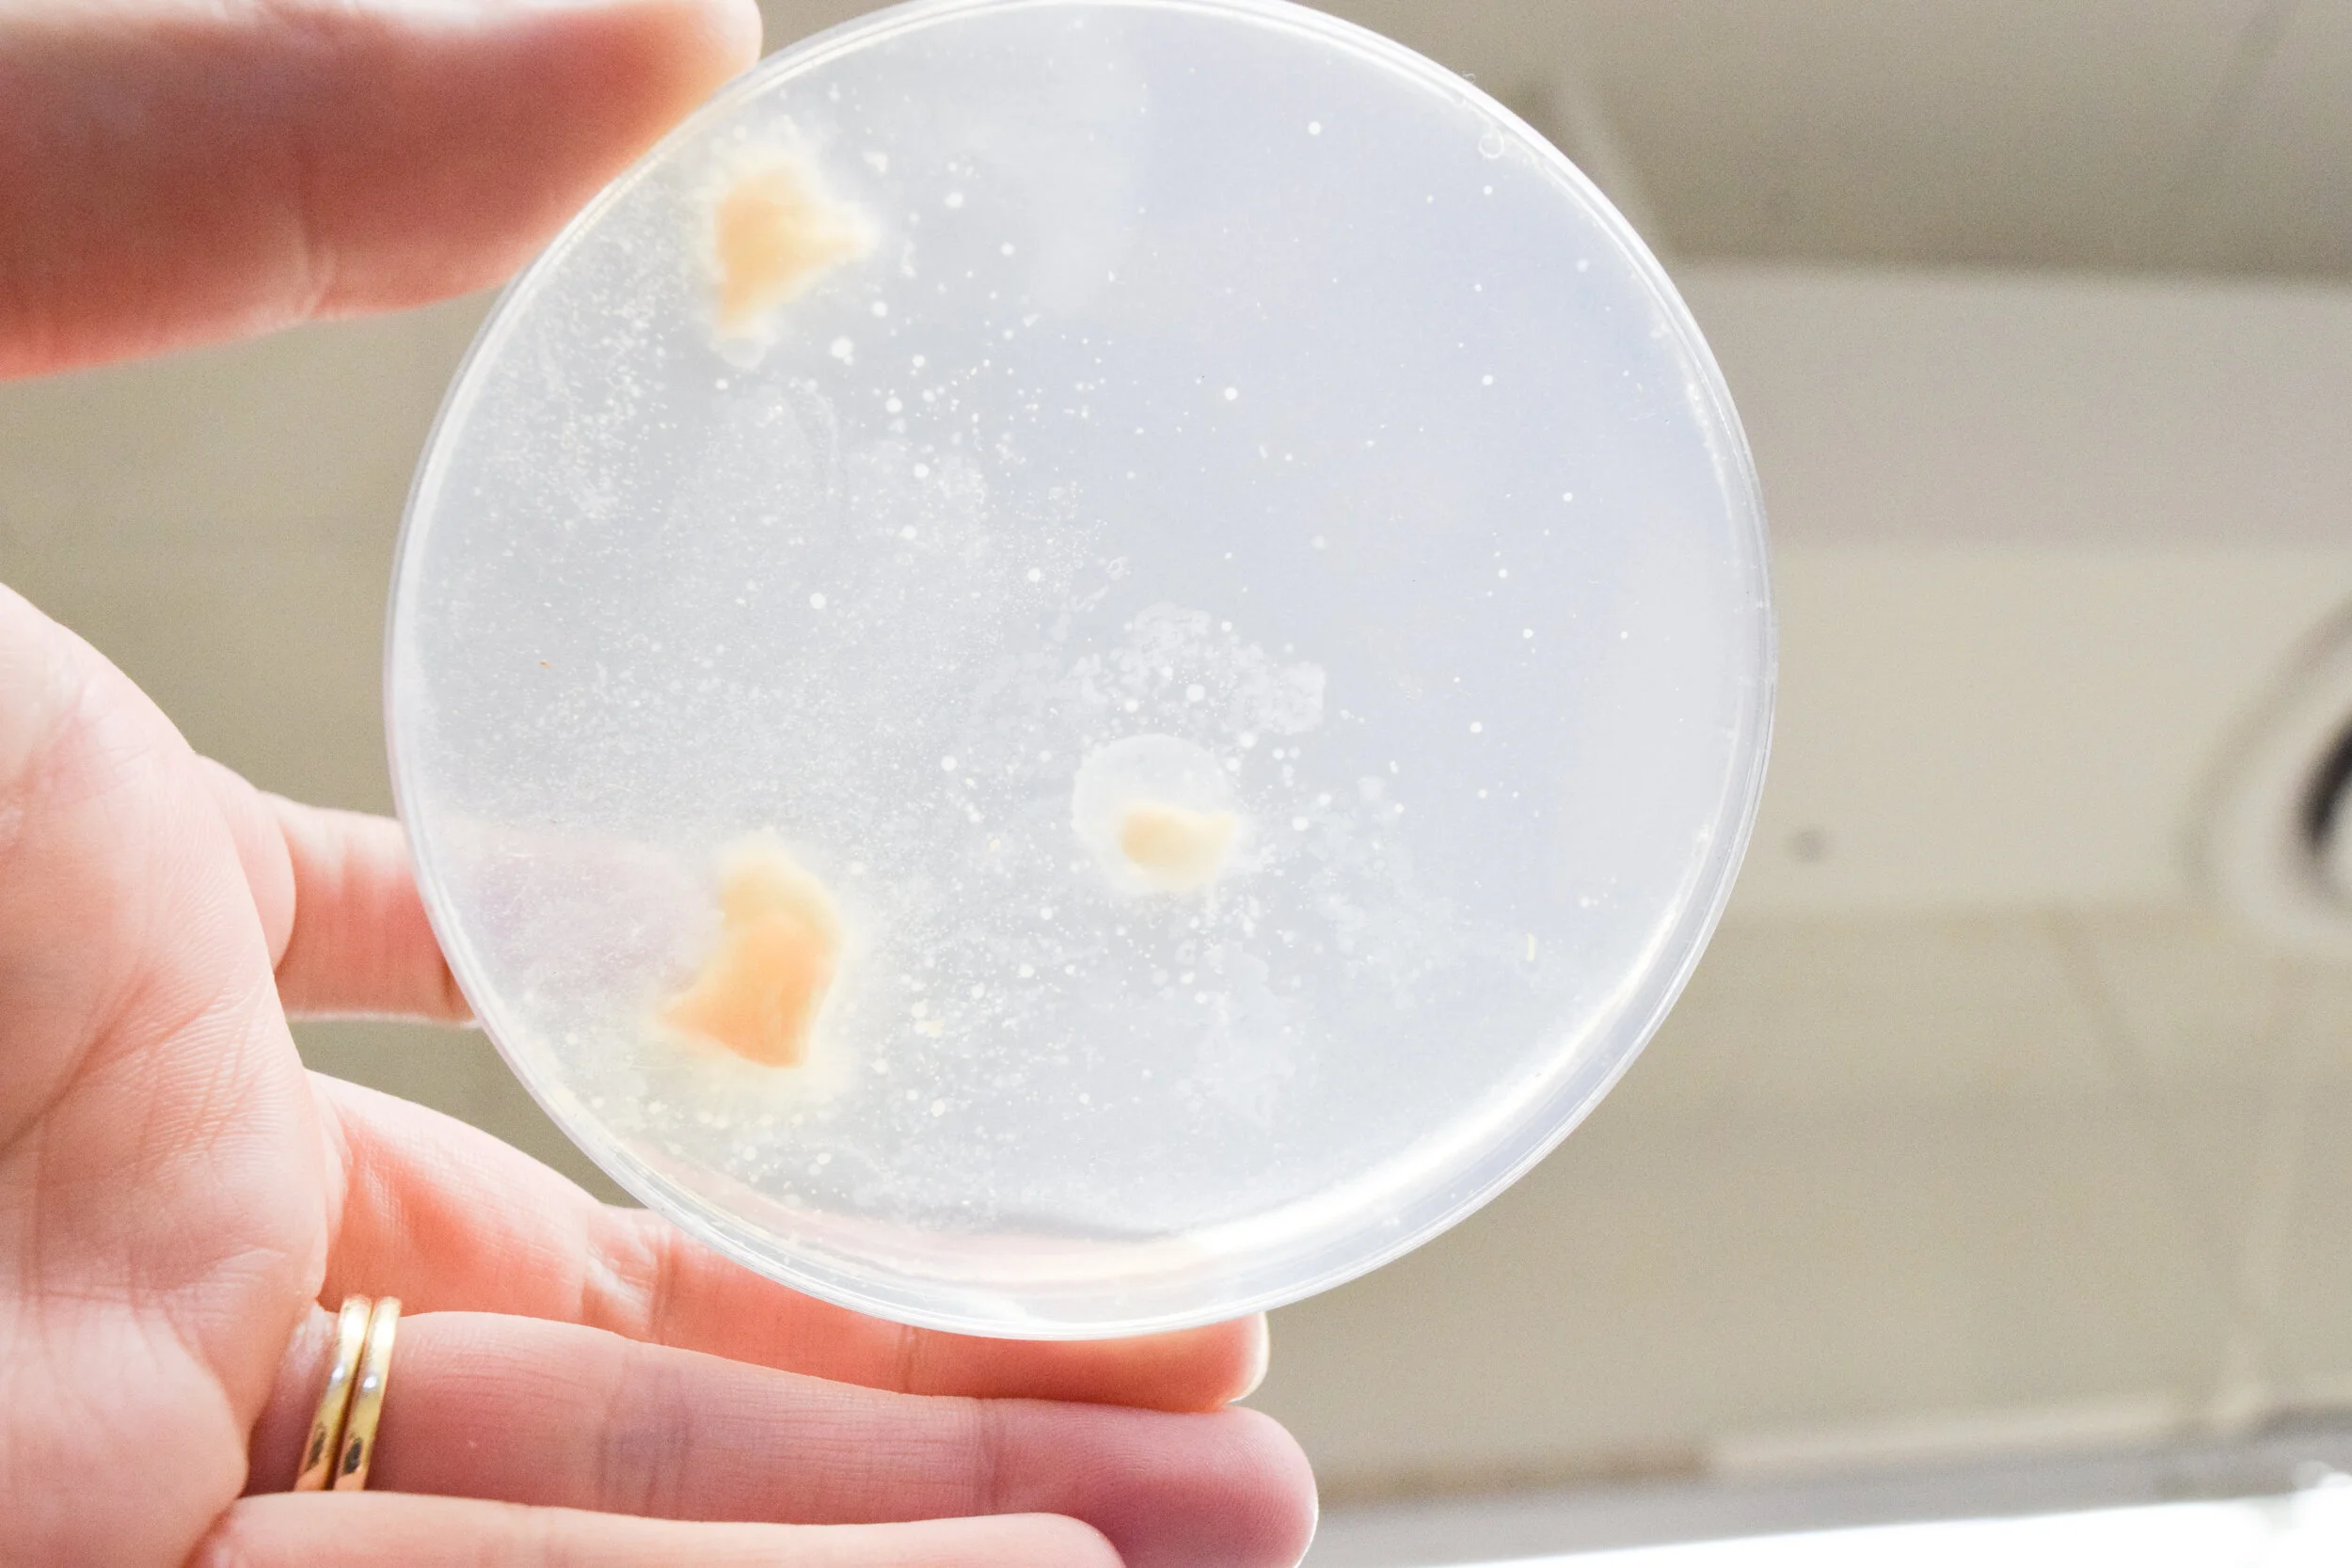

Mycelium Building Material Development + Research.
A study in novel renewable, upcycled building materials. The project is attempting to answer the creative throttle in “sustainable” design of less.
More to come soon.
Trials are currently underway in material development, with aspirations of a digitally fabricated application, much like the Generative Habitat.